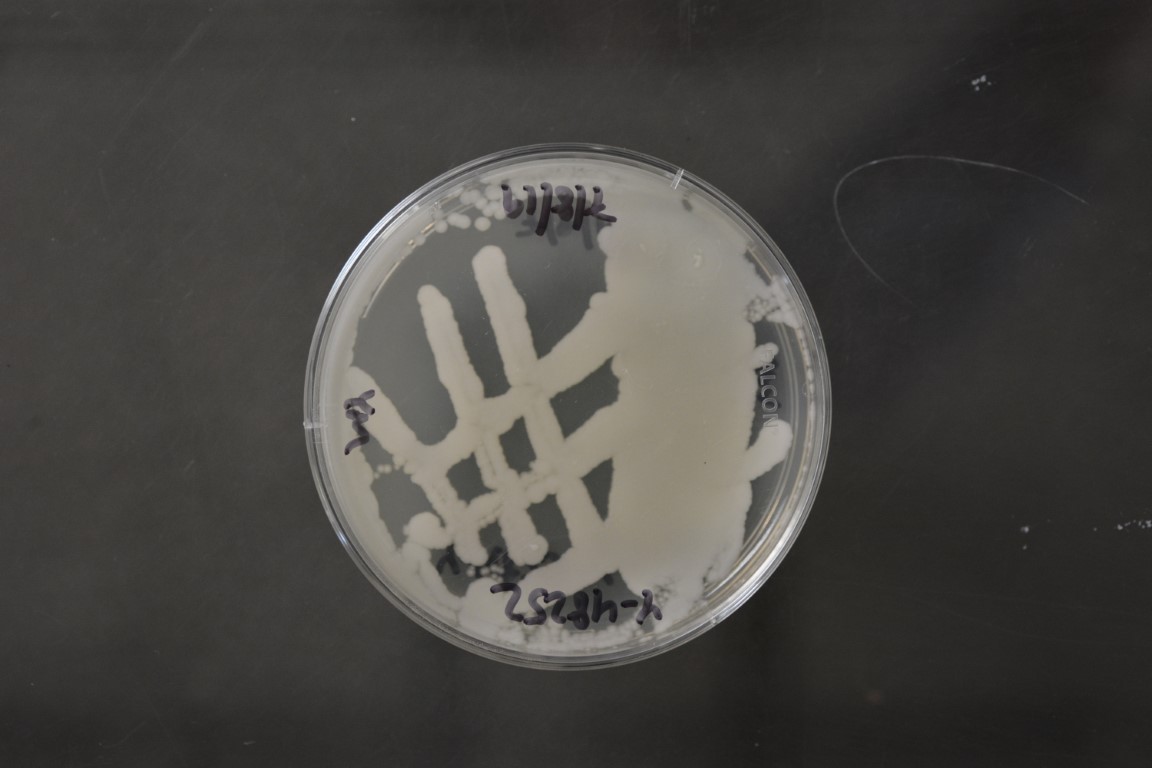

Candida oslonensis
NRRL Y-48252(Type Strain)
Accession numbers in other collections:CBS 10146=VI 03316
Source:Vincent Robert,CBS,Utrecht,The Netherlands
Isolated from(substrate):DFD,yogurt with kiwi
Substrate location:Oslo,Norway
Genetic info:GenBank:D1/D2(AM268477),ITS(AM279265).
Growth media:Yeast Extract-Malt Extract-Peptone-Glucose(YM for yeasts)(number 6)
Optimum growth temperature:25C
Strain images:
NRRL_Y-48252_6.JPG

Comments:Yarrowia clade,Mycobank number MB 510769